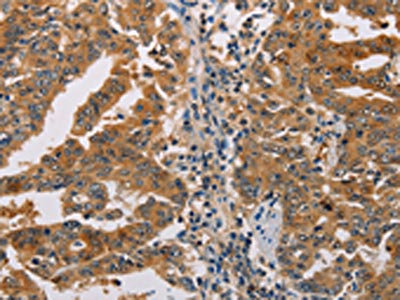

-
中文名稱:ACY1兔多克隆抗體
-
貨號:CSB-PA616041
-
規格:¥1100
-
圖片:
-
The image on the left is immunohistochemistry of paraffin-embedded Human gastic cancer tissue using CSB-PA616041(ACY1 Antibody) at dilution 1/25, on the right is treated with fusion protein. (Original magnification: ×200)
-
The image on the left is immunohistochemistry of paraffin-embedded Human colon cancer tissue using CSB-PA616041(ACY1 Antibody) at dilution 1/25, on the right is treated with fusion protein. (Original magnification: ×200)
-
Gel: 10%SDS-PAGE, Lysate: 40 μg, Lane 1-3: Mouse kidney tissue, human normal kidney tissue, K562 cells, Primary antibody: CSB-PA616041(ACY1 Antibody) at dilution 1/250, Secondary antibody: Goat anti rabbit IgG at 1/8000 dilution, Exposure time: 2 minutes
-
-
其他:
產品詳情
-
Uniprot No.:
-
基因名:ACY1
-
別名:ACY 1 antibody; ACY-1 antibody; Acy1 antibody; ACY1_HUMAN antibody; ACY1D antibody; ACYLASE antibody; Acylase I antibody; Aminoacylase 1 antibody; Aminoacylase-1 antibody; EC 3.5.1.14 antibody; epididymis secretory protein Li 5 antibody; HEL-S-5 antibody; N acyl L amino acid amidohydrolase antibody; N-acyl-L-amino-acid amidohydrolase antibody; OTTHUMP00000212459 antibody; OTTHUMP00000212462 antibody; OTTHUMP00000212463 antibody; OTTHUMP00000212464 antibody; OTTHUMP00000212465 antibody
-
宿主:Rabbit
-
反應種屬:Human,Mouse
-
免疫原:Fusion protein of Human ACY1
-
免疫原種屬:Homo sapiens (Human)
-
標記方式:Non-conjugated
-
抗體亞型:IgG
-
純化方式:Antigen affinity purification
-
濃度:It differs from different batches. Please contact us to confirm it.
-
保存緩沖液:-20°C, pH7.4 PBS, 0.05% NaN3, 40% Glycerol
-
產品提供形式:Liquid
-
應用范圍:ELISA,WB,IHC
-
推薦稀釋比:
Application Recommended Dilution ELISA 1:2000-1:5000 WB 1:200-1:1000 IHC 1:25-1:100 -
Protocols:
-
儲存條件:Upon receipt, store at -20°C or -80°C. Avoid repeated freeze.
-
貨期:Basically, we can dispatch the products out in 1-3 working days after receiving your orders. Delivery time maybe differs from different purchasing way or location, please kindly consult your local distributors for specific delivery time.
-
用途:For Research Use Only. Not for use in diagnostic or therapeutic procedures.
相關產品
靶點詳情
-
功能:Catalyzes the hydrolysis of N-acetylated amino acids to acetate and free amino acids.
-
基因功能參考文獻:
- with the elevated level in the disease progression of Chronic hepatitis B (CHB), ACY1 autoantibody may be a valuable serum biomarker for discriminating HBVrelated liver cirrhosis from CHB. PMID: 27633755
- Biochemical analysis showed absence of ACY1 enzyme activity in the patient's fibroblasts. PMID: 24117009
- ACY1 acts as a tumor suppressor in hepatocellular carcinoma. PMID: 24846301
- Report serum aminoacylase-1 as a novel biomarker with potential prognostic utility for long-term outcome in renal transplant recipients with delayed graft function. PMID: 23739232
- Case Report: ACY1-deficient patient presenting with autistic features. PMID: 20480396
- We concluded that ACY1 expression in colorectal cancer varies with stage and appears to play a role in cell proliferation and apoptosis PMID: 23317546
- These data suggest that aminoacylase expression is dysregulated in neuroblastoma. PMID: 21128244
- aminoacylase 1 proteins with the mutations p.Arg378Trp, p.Arg378Gln and p.Arg393His were also detected in Western blot analysis PMID: 21414403
- by complementing different active site mutants of human aminoacylase-1, study shows that catalysis occurs at the dimer interface PMID: 12933810
- first report of a patient with aminoacylase I deficiency PMID: 16274666
- Genetic deficiency of ACY1 leads to functional ACY1 deficiency and excretion of N-acetylated amino acids. PMID: 16465618
- Because hK1 amidase activity is significantly lower in urine of systolic HF patients, it can be supposed that activity of renal kallikrein-kinin system may be suppressed in this systolic heart failure. PMID: 17045186
- T347S variant of human Acy1 exhibited markedly increased catalytic efficiency against N-benzoylamino acids PMID: 18341290
顯示更多
收起更多
-
相關疾病:Aminoacylase-1 deficiency (ACY1D)
-
亞細胞定位:Cytoplasm.
-
蛋白家族:Peptidase M20A family
-
組織特異性:Expression is highest in kidney, strong in brain and weaker in placenta and spleen.
-
數據庫鏈接:
Most popular with customers
-
-
YWHAB Recombinant Monoclonal Antibody
Applications: ELISA, WB, IHC, IF, FC
Species Reactivity: Human, Mouse, Rat
-
-
-
-
-
-